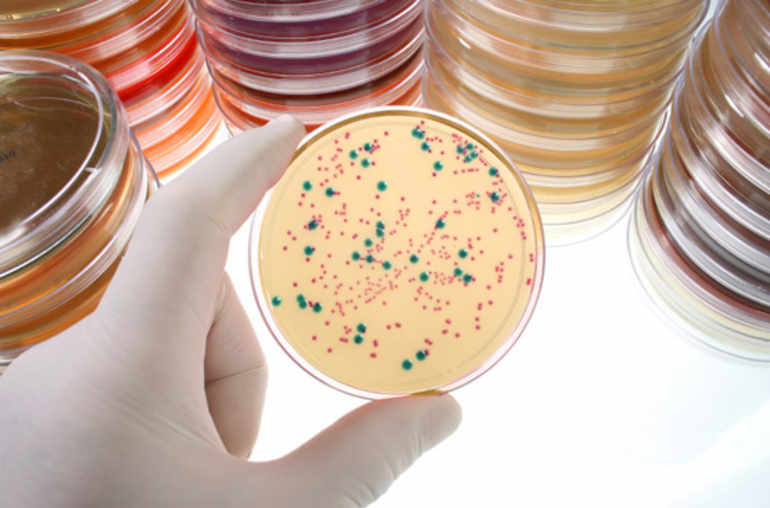

Le microbiote intestinal est un trésor pour la santé
De quoi on parle?
Les faits
On connaissait son existence, mais il y a quelques années encore on sous-estimait son rôle. Le microbiote intestinal, constitué de milliards de bactéries, est désormais considéré comme un organe à part entière dont les dérèglements peuvent provoquer des troubles aussi divers que l’obésité, le diabète, les maladies inflammatoires intestinales ou même des changements de comportement.
C’est le microbiote intestinal qui, sous la loupe des chercheurs et médecins, n’en finit pas de révéler ses trésors.
Cette flore intestinale, comme on l’appelait auparavant, est constituée de 100 000 milliards de bactéries – dix fois plus que le nombre de cellules du corps! Des micro-organismes inoffensifs avec lesquels l’être humain a évolué et qui vivent en parfaite symbiose avec lui. Ce qui fait dire à Philippe Sansonetti, professeur au Collège de France à Paris et spécialiste des maladies infectieuses, que «l’homme est un hybride primate-microbe».
Ce bestiaire remplit de multiples fonctions. Il est un élément clé de la digestion des aliments – il dégrade les fibres alimentaires qui, sans lui, ne pourraient pas être digérées – et synthétise certaines vitamines. Il intervient aussi dans la maturation du système immunitaire.
Mais plus important encore, selon Philippe Sansonetti, le microbiote nous protège contre des bactéries étrangères, en particulier pathogènes. «C’est la loi du premier occupant»: grâce à ces microbes, «légitimement installés dans nos intestins, il est plus difficile pour un intrus de s’y insérer.»
Diversité des espèces
Le système digestif abrite plusieurs centaines d’espèces bactériennes dont l’équilibre et la diversité sont garants de la santé. C’est dire que lorsque l’harmonie entre les populations microbiennes est rompue, divers troubles peuvent se développer ou s’aggraver.
A commencer par l’obésité. Des chercheurs américains ont réussi à faire grossir des souris minces simplement en leur transplantant la flore intestinale de souris obèses. Preuve que les bactéries ont un impact sur la régulation du stockage des graisses dans le tissu adipeux. Chez les humains, l’analyse des matières fécales a d’ailleurs révélé que le microbiote des personnes obèses était différent de celui du reste de la population. La composition de la flore bactérienne a aussi un impact sur le développement de maladies inflammatoires chroniques de l’intestin. Chez les individus souffrant de la maladie de Crohn, on a constaté l’absence, ou la sous-représentation, de certaines espèces bactériennes ayant un rôle anti-inflammatoire. Toutefois, constate Philippe Sansonetti, «on ne sait pas si c’est l’inflammation de l’intestin qui altère la flore ou si c’est l’inverse. En revanche, il paraît acquis que le déséquilibre du microbiote entretient ces pathologies.»
Il est aussi admis que les bactéries intestinales sont indispensables à la maturation du système immunitaire des enfants. Les nouveau-nés, qui étaient stériles in utero, développent leur microbiote au cours des deux premières années de leur vie; d’abord en entrant en contact avec les bactéries maternelles à leur naissance, puis en côtoyant les microbes présents dans l’environnement. Or, avec l’hygiénisme ambiant et l’utilisation massive d’antibiotiques qui détruisent certaines populations bactériennes, «en une ou deux générations, le système immunitaire a perdu ses repères», selon Philippe Sansonetti. Le chercheur y voit l’une des causes possibles de la «flambée actuelle de pathologies comme l’eczéma, l’asthme ou la sclérose en plaques», toutes liées à des dérèglements immunitaires. Cela pourrait même expliquer l’augmentation de l’obésité, puisqu’aux Etats-Unis «on a constaté que les enfants qui ont reçu un traitement antibiotique prolongé ont un risque accru de 20% de devenir obèses».
Modification des comportements
Nichées dans les intestins, les bactéries agissent bien au-delà de notre ventre puisqu’elles peuvent même modifier les comportements de leur hôte. Si l’on croise les microbiotes d’une souris «docile» et d’une autre «agressive», la première devient belliqueuse et la seconde obéissante. «Sous la pression du microbiote, l’intestin fabrique diverses substances, notamment des hormones et des neurotransmetteurs, qui peuvent passer la barrière hémato-encéphalique», explique Philippe Sansonetti. En traversant cette membrane, ces molécules peuvent pénétrer dans le cerveau et modifier son fonctionnement. «Il n’est pas sûr qu’un tel processus puisse influencer les adultes. Mais il peut agir sur les cerveaux des bébés.» Certains chercheurs évoquent d’ailleurs déjà un lien entre le microbiote et le développement de l’autisme.
Et ce n’est qu’un début. Le décryptage récent des génomes des bactéries intestinales a donné un coup d’accélérateur aux recherches concernant le microbiote et ses implications sur la santé. Cet organe insaisissable n’a pas donc fini de faire parler de lui.
Les premières pistes thérapeutiques
Puisqu’un déséquilibre dans les populations bactériennes qui peuplent les intestins peut provoquer diverses maladies, il est logique d’imaginer de traiter ces pathologies en modifiant la composition du microbiote.
Cela semble être le cas dans la lutte contre Clostridium difficile, une bactérie pathogène produisant des toxines qui peuvent être fatales. Pour la combattre, des médecins australiens, rapidement suivis par leurs collègues américains et européens, ont entrepris de transférer dans les intestins de leurs patients des extraits fécaux issus des selles de personnes saines. La méthode est efficace puisqu’elle permet «d’arrêter le développement de la colite (la forme la plus sévère de la maladie) et d’éviter les rechutes», constate Philippe Sansonetti, professeur au Collège de France à Paris. Il s’agit de «résultats brillants, ajoute-t-il, mais dont la portée reste limitée».
D’autres essais cliniques de transplantations fécales sont en cours. Notamment aux Pays-Bas où des médecins les ont testées sur des patients obèses et souffrant de résistance à l’insuline – donc ayant un risque important de développer un diabète. L’intervention semble protéger contre cette dernière maladie, mais elle n’a aucun effet amaigrissant.
Reste que les transplantations d’extraits fécaux posent des «problèmes de sécurité», souligne Philippe Sansonetti, car même si le donneur est en bonne santé, on ne maîtrise pas le contenu microbien de ses selles. Il serait plus sûr d’agir sur le microbiote des malades en enrichissant leur alimentation avec des probiotiques (des bactéries vivantes) ou des prébiotiques (qui sont des sources d’énergie pour certains micro-organismes intestinaux). La piste est actuellement explorée, mais «elle n’a pas donné jusqu’ici de résultats concluants», d’après Philippe Sansonetti.
Selon lui, c’est aux jeunes enfants, qui acquièrent une partie de leur flore intestinale à la naissance, qu’il faudrait s’intéresser tout particulièrement. Le chercheur français prévoit d’ailleurs l’émergence d’une nouvelle médecine périnatale qui prendra en compte les connaissances accumulées sur le microbiote. Il se dit aussi persuadé qu’à l’avenir, «on va devenir plus prudent sur l’administration prolongée d’antibiotiques aux tout petits».





